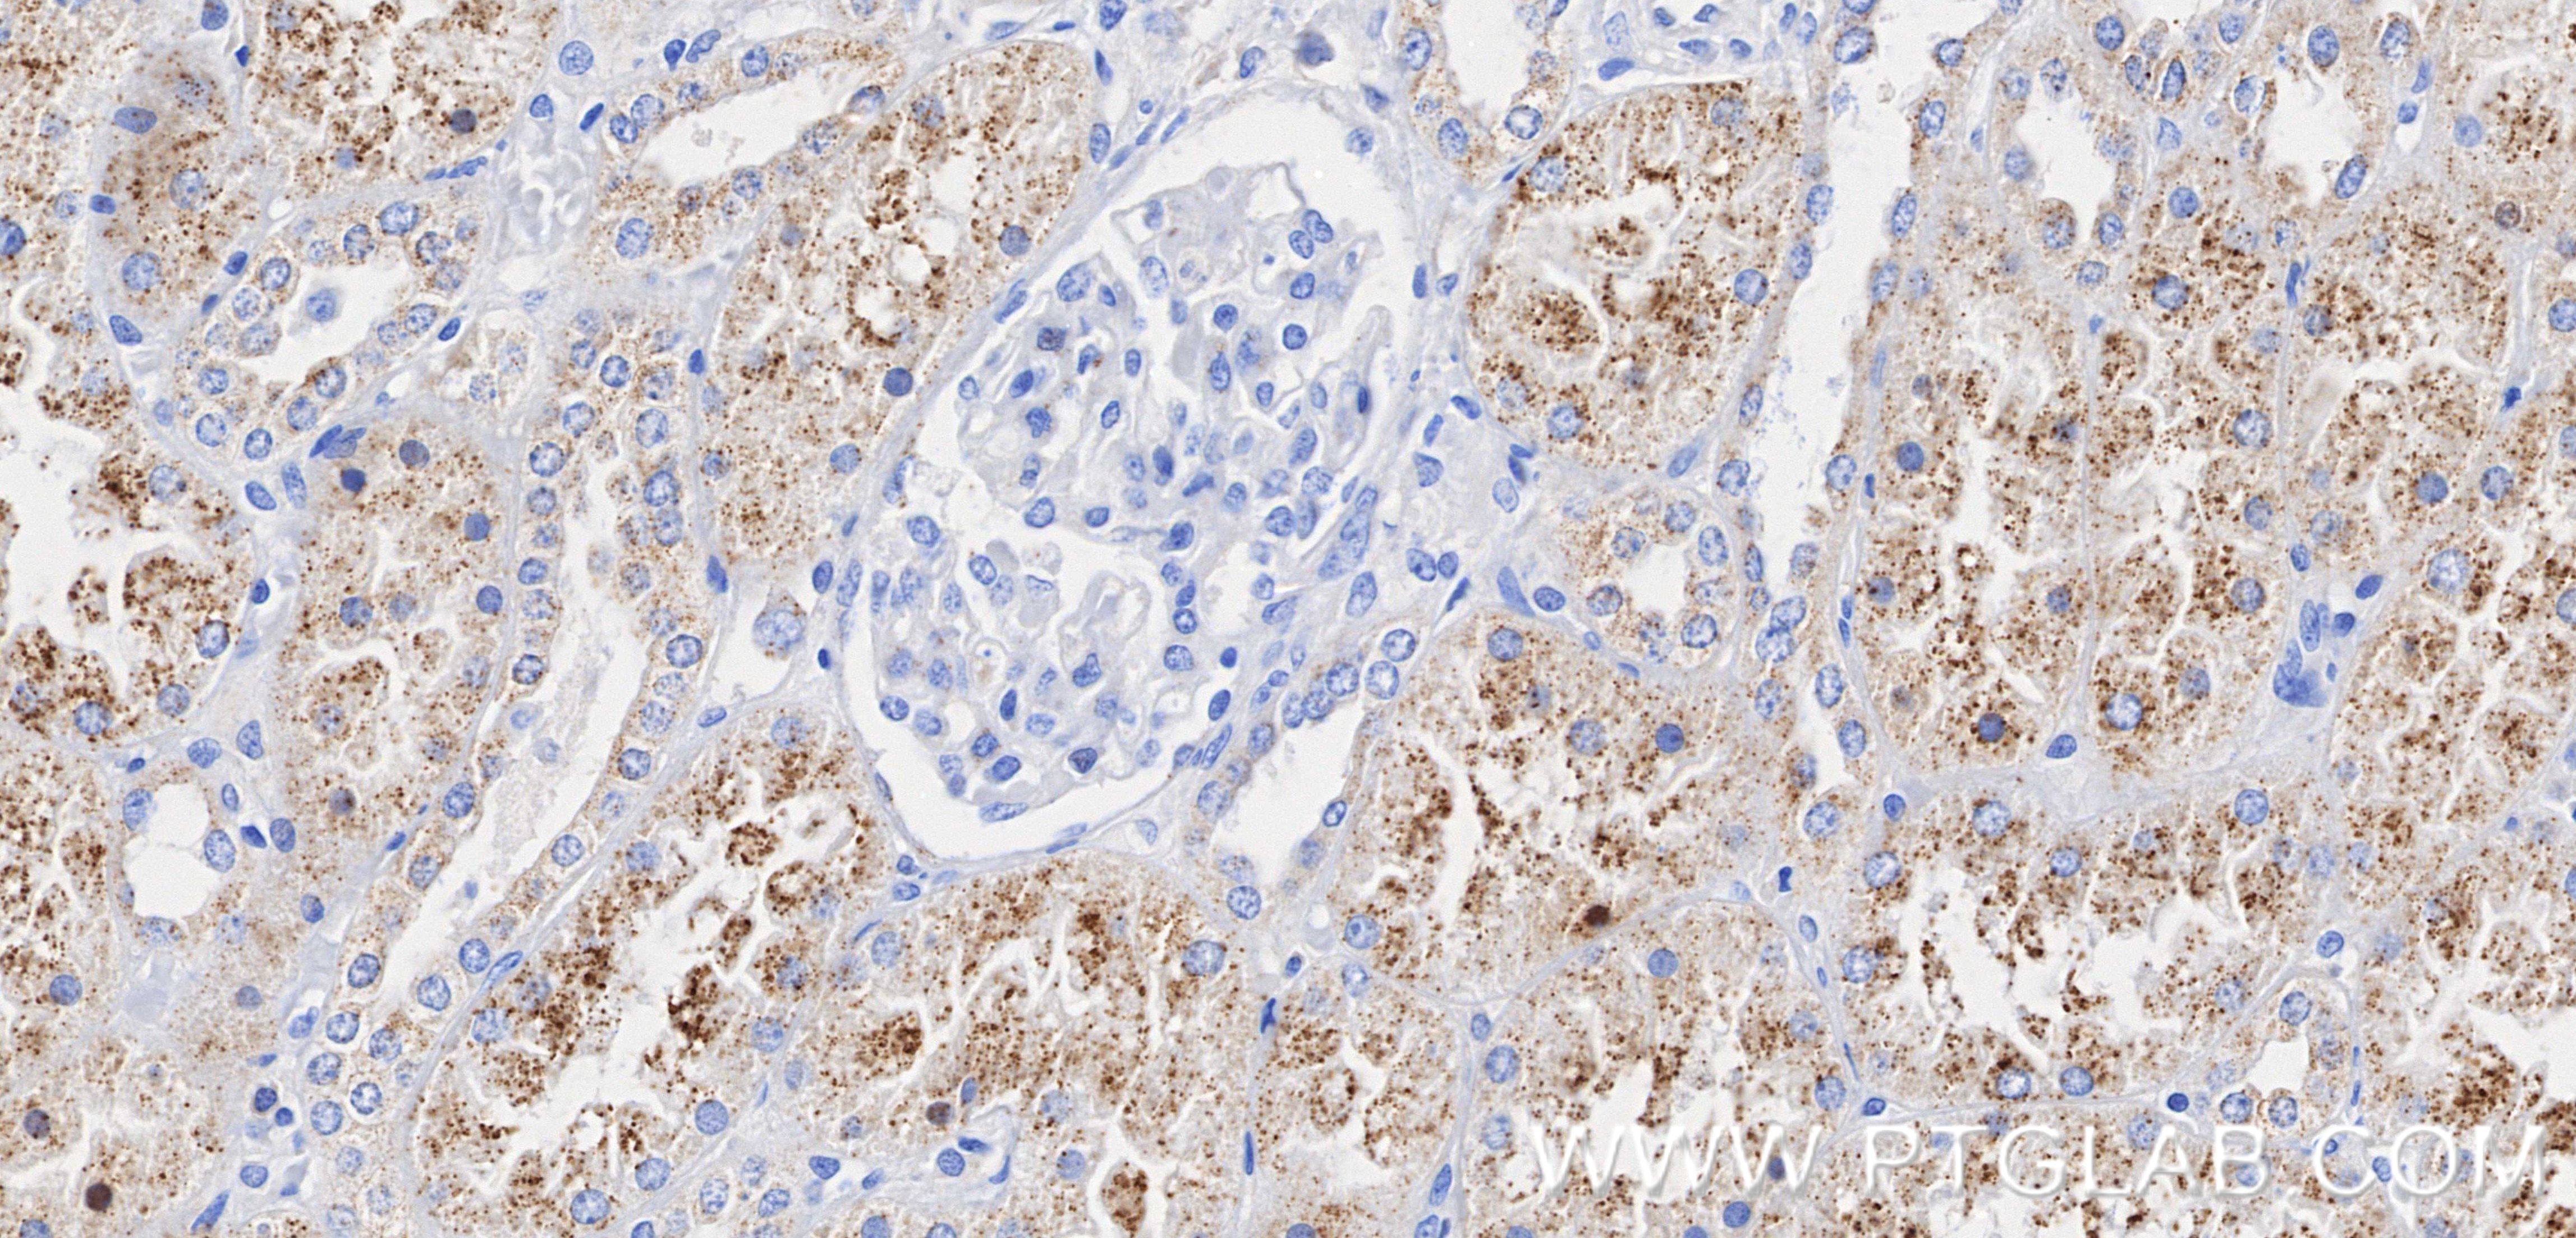
Immunohistochemical analysis of paraffin-embedded human kidney tissue slide using 87579-1-RR (EHHADH antibody) at dilution of 1:1000 (under 40x lens). Heat mediated antigen retrieval with Tris-EDTA buffer (pH 9.0). Immunohistochemistry (IHC) staining of human kidney tissue using EHHADH Recombinant monoclonal antibody (87579-1-RR)

Tested Applications
| Positive WB detected in | mouse kidney tissue, rat kidney tissue, mouse liver tissue, rat liver tissue |
| Positive IHC detected in | human kidney tissue Note: suggested antigen retrieval with TE buffer pH 9.0; (*) Alternatively, antigen retrieval may be performed with citrate buffer pH 6.0 |
Recommended dilution
| Application | Dilution |
|---|---|
| Western Blot (WB) | WB : 1:5000-1:50000 |
| Immunohistochemistry (IHC) | IHC : 1:500-1:2000 |
| It is recommended that this reagent should be titrated in each testing system to obtain optimal results. | |
| Sample-dependent, Check data in validation data gallery. | |
Product Information
87579-1-RR targets EHHADH in WB, IHC, ELISA applications and shows reactivity with human, mouse, rat samples.
| Tested Reactivity | human, mouse, rat |
| Host / Isotype | Rabbit / IgG |
| Class | Recombinant |
| Type | Antibody |
| Immunogen |
CatNo: Ag24237 Product name: Recombinant human EHHADH protein Source: e coli.-derived, PET28a Tag: 6*His Domain: 108-284 aa of BC038948 Sequence: GCHYRIAHAEAQVGLPEVTLGLLPGARGTQLLPRLTGVPAALDLITSGRRILADEALKLGILDKVVNSDPVEEAIRFAQRVSDQPLESRRLCNKPIQSLPNMDSIFSEALLKMRRQHPGCLAQEACVRAVQAAVQYPYEVGIKKEEELFLYLLQSGQARALQYAFFAERKANKWSTP Predict reactive species |
| Full Name | enoyl-Coenzyme A, hydratase/3-hydroxyacyl Coenzyme A dehydrogenase |
| Calculated Molecular Weight | 723 aa, 79 kDa |
| Observed Molecular Weight | 69 kDa |
| GenBank Accession Number | BC038948 |
| Gene Symbol | EHHADH |
| Gene ID (NCBI) | 1962 |
| Conjugate | Unconjugated |
| Form | Liquid |
| Purification Method | Protein A purification |
| UNIPROT ID | Q08426 |
| Storage Buffer | PBS with 0.02% sodium azide and 50% glycerol, pH 7.3. |
| Storage Conditions | Store at -20°C. Stable for one year after shipment. Aliquoting is unnecessary for -20oC storage. 20ul sizes contain 0.1% BSA. |
Background Information
EHHADH, as the "bifunctional catalytic center" of peroxisome fatty acid β-oxidation, its expression and activity directly affect energy metabolism, inflammation level and cell fate. Gene defect causes serious neuro-renal tubular lesions, and abnormal expression is closely related to modern chronic diseases such as obesity, diabetes and tumor, which is one of the hot metabolic enzymes concerned by basic research and clinical transformation. It is mainly located in peroxisome, and some activity can be detected in mitochondrial inner membrane, and it is highly expressed in liver, kidney, heart and other organs.
Protocols
| Product Specific Protocols | |
|---|---|
| IHC protocol for EHHADH antibody 87579-1-RR | Download protocol |
| WB protocol for EHHADH antibody 87579-1-RR | Download protocol |
| Standard Protocols | |
|---|---|
| Click here to view our Standard Protocols |